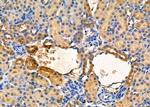
Renalase Antibody in Immunohistochemistry (Paraffin) (IHC (P))

Search
Invitrogen
Renalase Polyclonal Antibody
{{$productOrderCtrl.translations['antibody.pdp.commerceCard.promotion.promotions']}}
{{$productOrderCtrl.translations['antibody.pdp.commerceCard.promotion.viewpromo']}}
{{$productOrderCtrl.translations['antibody.pdp.commerceCard.promotion.promocode']}}: {{promo.promoCode}} {{promo.promoTitle}} {{promo.promoDescription}}. {{$productOrderCtrl.translations['antibody.pdp.commerceCard.promotion.learnmore']}}
图: 1 / 3
Renalase Antibody (PA5-103006) in ICC/IF

Please note: We are reviewing Western blot images included in the antibody testing data in our catalog, including those provided by third parties. Unless expressly labeled or annotated as “raw-unedited”, Western blot images included in the antibody testing data in our catalog may have been edited, optimized or otherwise adjusted for presentation.
产品信息
PA5-103006
种属反应
宿主/亚型
分类
类型
抗原
偶联物
形式
浓度
规格
纯化类型
保存液
内含物
保存条件
运输条件
RRID
产品详细信息
Antibody detects endogenous levels of total RNLS.
靶标信息
Renalase is a flavoprotein enzyme encoded by the RNLS gene, primarily expressed in the kidneys and heart where it plays a critical role in metabolizing catecholamines and catecholamine-like substances. It utilizes nicotinamide adenine dinucleotide (NADH) as a cofactor and operates through a superoxide-dependent mechanism, which is distinct from monoamine oxidase pathways. Renalase is considered a novel renal hormone that influences blood pressure and cardiac function by regulating circulating catecholamines. Its genetic variants have been associated with essential hypertension, highlighting its importance in cardiovascular health. In diabetic nephropathy, renalase exhibits protective effects, as demonstrated in genetically modified mouse models. These models have shown that renalase overexpression can mitigate renal damage, suggesting therapeutic potential. Renalase's expression is highest in the proximal tubules of the kidneys, which are densely innervated by sympathetic nerves, underscoring the connection between renalase and sympathetic nervous system activity. This enzyme's discovery has enriched our understanding of renal hormone regulation and its implications in diseases such as chronic kidney disease (CKD) and end-stage renal disease (ESRD).
仅用于科研。不用于诊断过程。未经明确授权不得转售。
篇参考文献 (0)
生物信息学
蛋白别名: alpha-NAD(P)H oxidase/anomerase; FLJ11218; HGNC:25641; MAO-C; mMAO-C; Monoamine oxidase-C; Renalase; rnls
基因别名: 6530404N21Rik; AI452315; AW060440; C10orf59; RGD1309804; Rnls
UniProt ID: (Rat) Q5U2W9
Entrez Gene ID: (Rat) 361751, (Mouse) 67795




